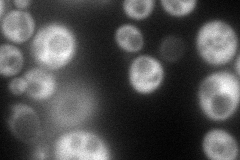
YNR051C
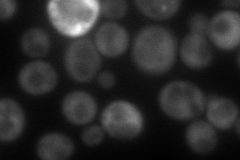
YNR051C
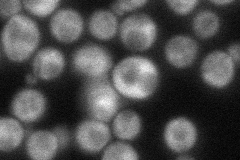
YNR051C
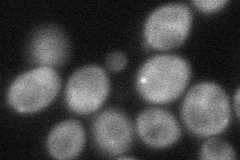
YNR051C
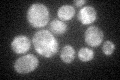
YNR051C

View description
Ubiquitin protease cofactor, forms deubiquitination complex with Ubp3p that coregulates anterograde and retrograde transport between the endoplasmic reticulum and Golgi compartments; null is sensitive to brefeldin A
Localization:
Intensity:
Fold change:
Significance:
-
C’ GFP library in SD

cytosol74.3 -
N' NOP1pr-GFP in SD
cytosol113.035 -
N' TEF2pr-mCherry in SD
cytosol113.983 -
N' NATIVEpr-GFP in SD
cytosol62.2406 -
N' TEF2pr-VC and Cyto-VN in SD
cytosol49.4851 -
C’ GFP library in SD+DTT

cytosol77.471.04No -
C’ GFP library in SD+H2O2

cytosol65.010.87No -
C’ GFP library in Starvation Media
cytosol38.690.52No -
C’ GFP library on the background of Pup2-DaMP

cytosol -
C’ GFP library on the background of CCT mutant

cytosol87.89151.18276No
